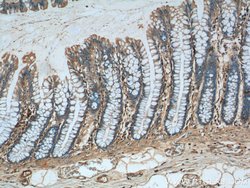
GNAS Rabbit anti-Human, Mouse, Polyclonal, Proteintech 150 &mu;L; Unconjugated:Antibodies,

missing translation for 'onlineSavingsMsg'
Learn More
Learn More
GNAS Rabbit anti-Human, Mouse, Polyclonal, Proteintech
Rabbit Polyclonal Antibody
Brand: Proteintech 10150-2-AP-150UL
This item is not returnable.
View return policy
Description
Mutations in GNAS gene result in pseudohypoparathyroidism type 1a, pseudohypoparathyroidism type 1b, Albright hereditary osteodystrophy, pseudopseudohypoparathyroidism, McCune-Albright syndrome, progressive osseus heteroplasia, polyostotic fibrous dysplasia of bone, and some pituitary tumors. This gene has a highly complex imprinted expression pattern. It encodes maternally, paternally, and biallelically expressed proteins which are derived from alternatively spliced transcripts with alternate 5′ exons. Each of the upstream exons is within a differentially methylated region, commonly found in imprinted genes. However, the close proximity (14 kb) of two oppositely expressed promoter regions is unusual. In addition, one of the alternate 5′ exons introduces a frameshift relative to the other transcripts, resulting in one isoform which is structurally unrelated to the others. An antisense transcript exists, and may regulate imprinting in this region. Mutations in this gene result in pseudohypoparathyroidism type 1a (PHP1a), which has an atypical autosomal domit inheritance pattern requiring maternal transmission for full penetrance.Specifications
| GNAS | |
| Polyclonal | |
| Unconjugated | |
| GNAS | |
| AHO, C20orf45, GNAS, GNAS complex locus, GNAS1, GPSA, GSA, GSP, NESP, PHP1A, PHP1B, POH | |
| Rabbit | |
| Antigen Affinity Chromatography | |
| RUO | |
| 14683, 2778 | |
| -20°C | |
| Liquid |
| Immunohistochemistry (Paraffin), Immunoprecipitation, Western Blot | |
| 0.17 mg/mL | |
| PBS with 50% glycerol and 0.1% sodium azide; pH 7.3 | |
| P84996, Q6R0H6 | |
| Gnas | |
| GNAS Fusion Protein Ag0197 | |
| 150 μL | |
| Primary | |
| Human, Mouse | |
| Antibody | |
| IgG |
Product Content Correction
Your input is important to us. Please complete this form to provide feedback related to the content on this product.
Product Title
Spot an opportunity for improvement?Share a Content Correction